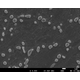
NK-D20-1-x5000.jpg

【医療機器向け】AXSIA-Zero3:高強度・高耐食性を追求
高強度・高耐食性を両立した析出硬化系ステンレスで、医療機器の品質向上に貢献。
医療機器業界では、耐食性、強度、耐摩耗性などの高度な機能性が求められます。 特に手術器具などは高機能な素材を求められています。 金属アレルギーのリスクを低減し、長期間にわたる使用に耐えうる材料選定が重要となります。 AXSIA-Zero3は、56~58HRCの高硬度とオーステナイト系ステンレスに匹敵する耐食性を有し、 医療機器の信頼性向上に貢献します。 【活用シーン】 ・手術器具 ・医療用高強度部品 ・その他、医療機器部品 【導入の効果】 ・高度な機能性実現 ・長期的な耐久性の確保 ・製品の信頼性向上
基本情報
【特長】 ・高硬度・高耐食性の高機能性:極低炭素,Si系の硬質金属間化合物の析出 ・高強度・高耐力:強度を利用した高機能部品や軽薄短小化への応用が可能 ・低熱処理寸法変化:低温度の時効硬化熱処理で高硬度化 ・熱処理設計の自由度:硬度の微調整が容易 【当社の強み】 シリコロイラボは、特殊ステンレス「シリコロイ」の技術開発・研究開発・販売を通じて、お客様の課題解決をサポートします。合金設計、熱処理設計、プロセス設計および技術サービス・技術提案に特化し、お客様の製品開発をスピーディーに支援します。
価格帯
納期
用途/実績例
【用途】 ■高機能部品 ■軽薄短小化 ※詳しくはPDFをダウンロードしていただくか、お気軽にお問い合わせください。
カタログ(1)
カタログをまとめてダウンロードおすすめ製品
取り扱い会社
シリコロイ「Silicolloy」はシリコン(ケイ素)を多量に含有するステンレスであり、純国産技術により誕生した画期的な新素材です。 ■『シリコロイ』は高強度、耐熱性(高温酸化性)、耐食性、耐摩耗性、高硬度、低熱処理寸法変化をひとつの鋼で備えるスーパーアロイです。■現在、多くのエンジニア(技術者・設計者)の間で製品化が進み、新商品開発、長寿命化によるトータルコストダウンに貢献しています。■析出硬化型ステンレスとしてトータルバランスに優れた『シリコロイA2』、析出硬化型として世界的にも最高硬度を有する『シリコロイXVI』があり、耐食性と高硬度を同時に必要とされる方は必見です!! 2025年、新素材『アクシアZeroシリーズ』を開発。 高耐食性・高硬度だけでなく、高強度・高耐力も備えた析出硬化系ステンレスの新素材です。『アクシアZero3』は56~58HRCの高硬度、オーステナイト系に相当する高い耐食性、さらに2000MPa級の高強度を実現。480℃相当の析出硬化処理によって硬度を得られるため、熱処理による変形や寸法変化を抑え、焼入れの諸問題を解決できる点も特長です。